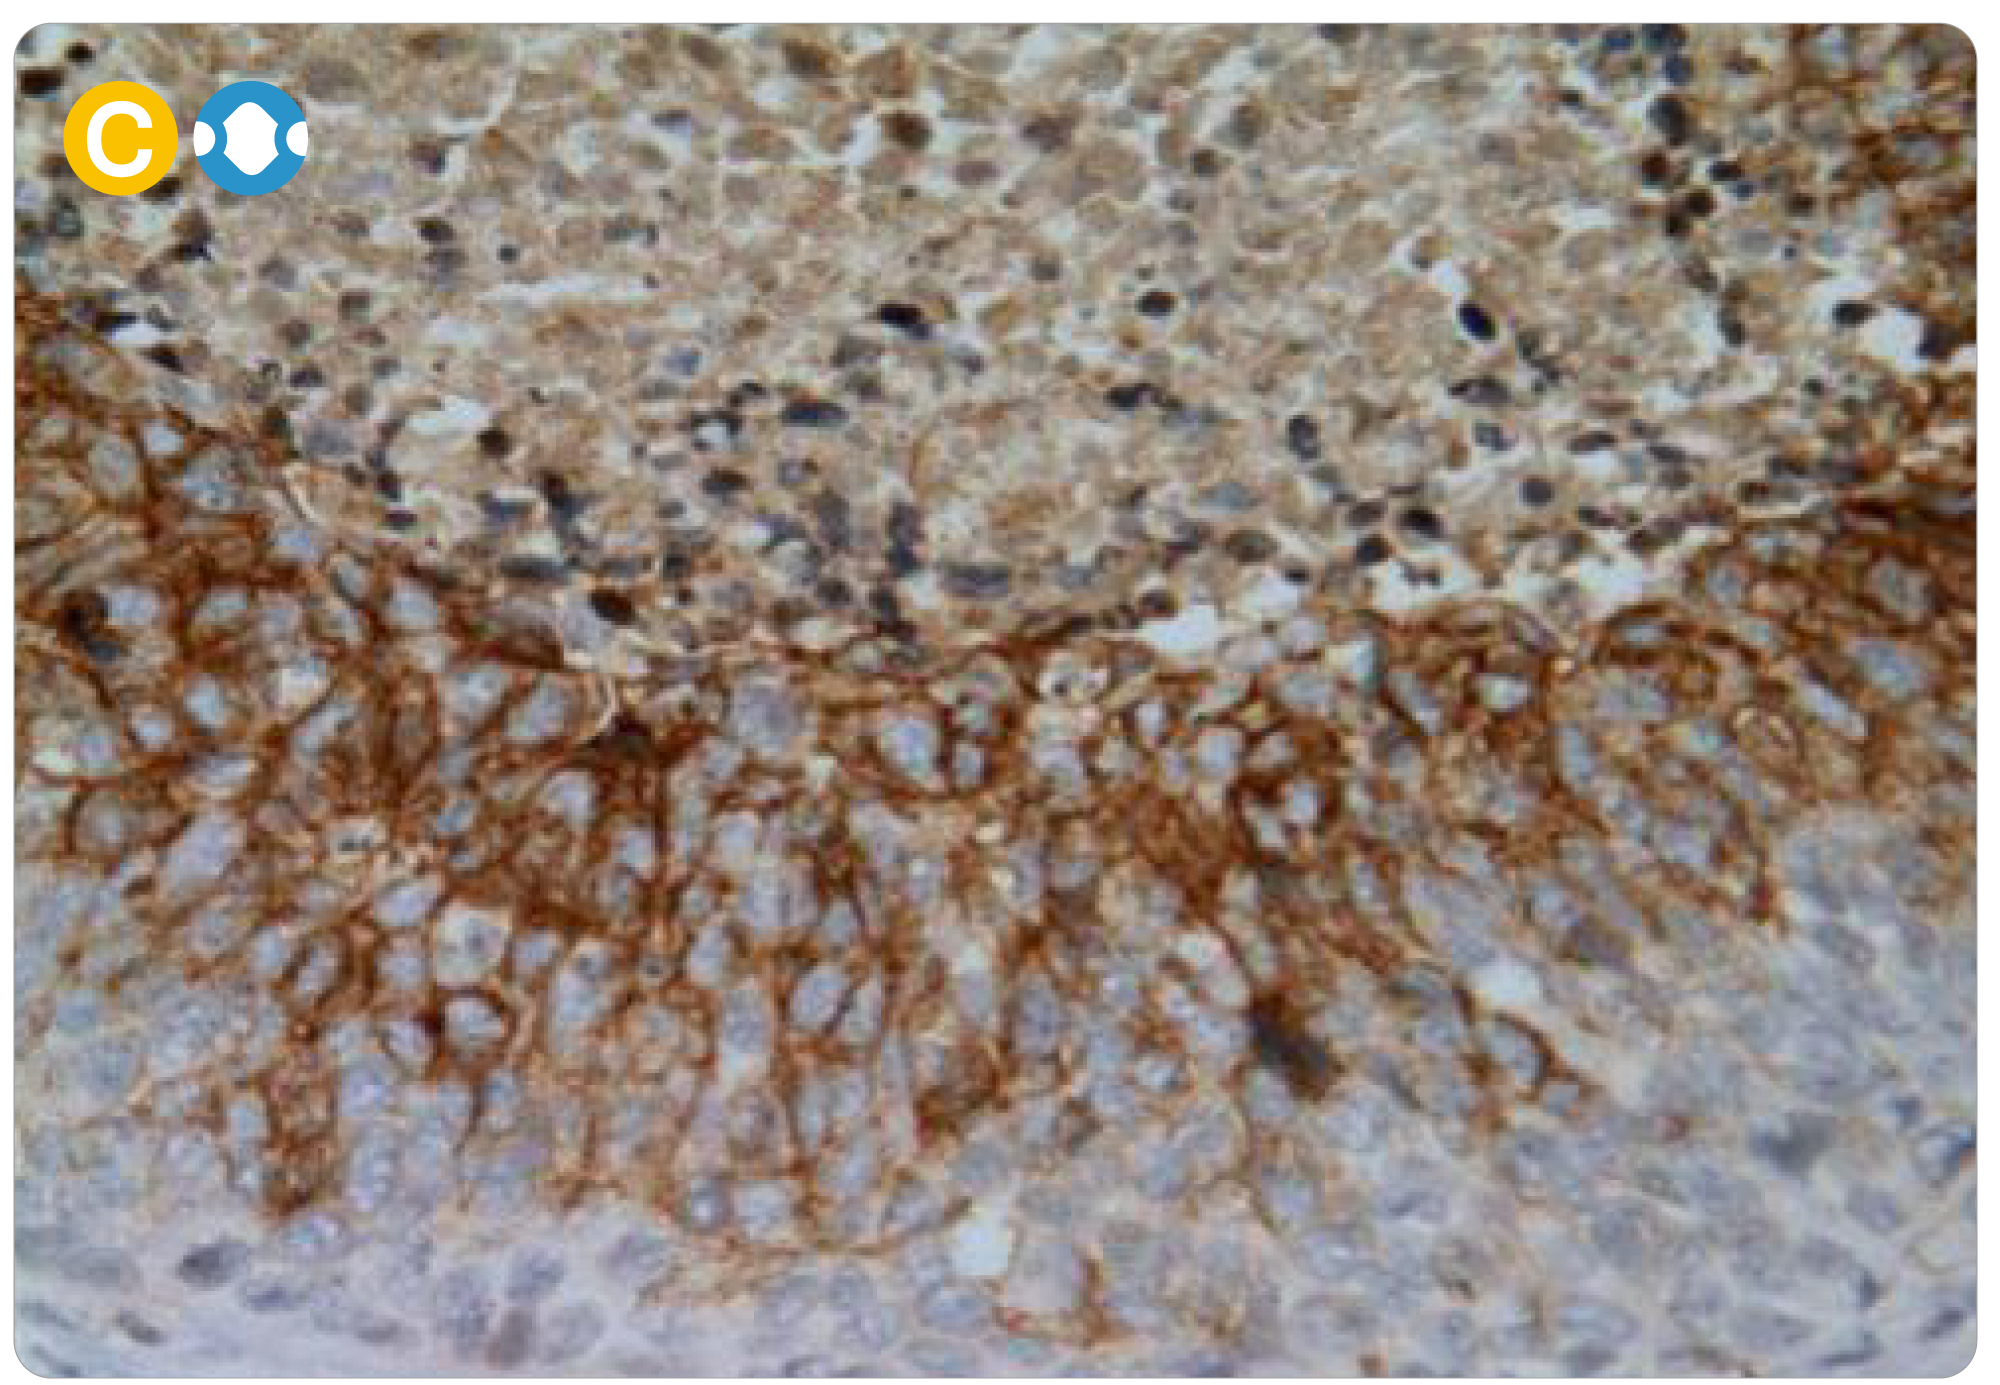
新闻图片9

公司新闻/正文
1368 人阅读发布时间:2022-08-19 09:44

CA IX是一种跨膜、缺氧诱导的锌金属酶,可将二氧化碳转化为碳酸氢盐和质子,这种酸碱调节功能对于维持促进恶性细胞存活和生长的碱性细胞内pH 值以及放大促进其侵袭和转移的细胞外酸中毒至关重要,表达CA IX的癌细胞通常代表异质性肿瘤中最具临床侵袭性的成分,使CA IX成为关键的生物标志物和主要的治疗靶点。
GeneTex 刚刚在其CA IX试剂目录中添加了一种新的兔重组单克隆抗体,作为其用于缺氧和癌症研究的全面产品组合的一部分;请参阅下面突出显示的产品并访问 www.genetex.com 了解更多详细信息。
热门研究抗体







Carbonic Anhydrase IX antibody [HL1410] (GTX636876)
Carbonic Anhydrase IX antibody [GT12] (GTX70020)

HIF1 alpha antibody (GTX127309)

Beclin 1 antibody (GTX133555)
重点产品
| 目录号 | 产品名 | 应用 |
| GTX121919 | EGFR antibody [N1-2], N-term | WB, ICC/IF, IHC-P, FACS, IP |
| GTX628887 | EGFR antibody [GT133] | WB, ICC/IF, IHC-P, IP |
| GTX635716 | EGFR (E746-A750del) antibody [HL363] | WB |
| GTX635834 | EGFR (L858R Mutant) antibody [HL1022] | WB |
| GTX132810 | EGFR (phospho Tyr1068) antibody | WB, ICC/IF, IHC-P |
| GTX133600 | EGFR (phospho Tyr845) antibody | WB, ICC/IF, IHC-P |
| GTX133431 | EGFR (phospho Tyr1045) antibody | WB, ICC/IF, IHC-P |
| GTX133435 | EGFR (phospho Tyr1148) antibody | WB, ICC/IF, IHC-P |
| GTX133599 | EGFR (phospho Tyr1086) antibody | WB, ICC/IF, IHC-P |
| GTX133601 | EGFR (phospho Tyr998) antibody | WB, ICC/IF, IHC-P |
| GTX133429 | EGFR (phospho Tyr992) antibody | WB, ICC/IF |
| GTX133425 | EGFR (phospho Thr669) antibody | WB |
| GTX133433 | EGFR (phospho Ser1046/Ser1047) antibody | WB |
| GTX100509 | Her2 / ErbB2 antibody | WB, IHC-P |
| GTX636940 | Her2 / ErbB2 (phospho Tyr1248) antibody [HL1466] | WB, IHC-P |
| GTX133445 | Her2 / ErbB2 (phospho Tyr1221/Tyr1222) antibody | WB, IHC-P |
| GTX130417 | Her2 / ErbB2 (phospho Tyr1139) antibody | WB |
| GTX133443 | Her2 / ErbB2 (phospho Tyr877) antibody | WB |
| GTX133602 | Her2 / ErbB2 (phospho Tyr1196) antibody | WB |
查看相关内容
参考文献
(1) Cancer Metastasis Rev. 2019 Jun;38(1-2):65-77.
更多详情请联系欣博盛生物科技
全国服务热线:4006-800-892
邮箱:market@neobioscience.com
深圳:0755-26755892
北京:010-88594029
上海:021-34613729
广州:020-87615159